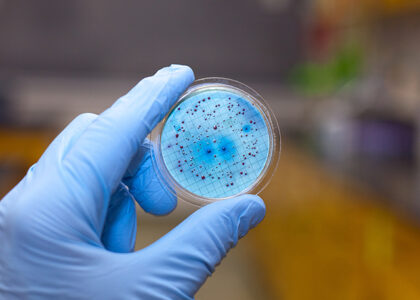
Antimicrobial-Coated Medical Devices Market

Global Antimicrobial-Coated Medical Devices Market to Soar Beyond USD 5,123.5 Million by 2033 Amid Rising Infection Prevention Measures | FMI
The global antimicrobial-coated medical devices market is poised for substantial growth, with its valuation expected